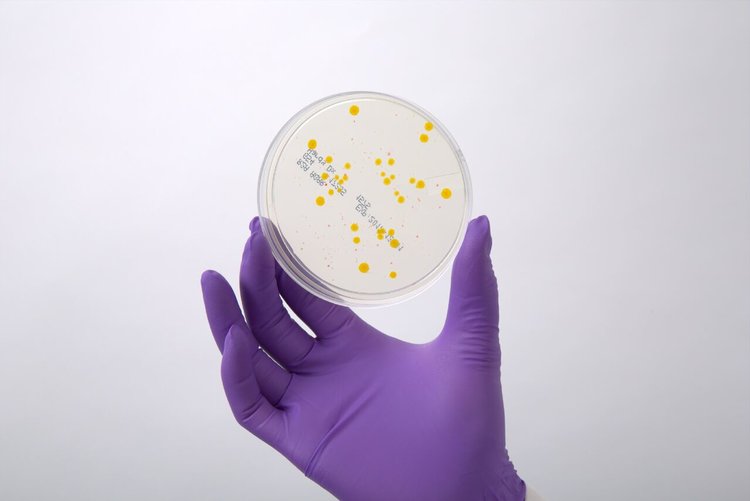
Dental research

Your cart is currently empty!

5 Effective Habits for Dental Unit Waterline Maintenance


Dental waterline disinfection is fast becoming a staple of respected practices the world over. There’s a lot of ideas out there about what works. Once you’ve implemented a regimen you’ve got to stick to it. Here are 5 daily habits every office should adopt to get the most out of their disinfection efforts.
1. No Unnecessary Purging
Purging the waterline is a common pitfall of dental offices caught up in the old school way of doing things. The idea was that since water is the medium in which bacteria grow, we remove the water from the equation and you cut off the cycle of growth. The problem with this idea is that bacteria can enter a waterline through the air and contaminate the unit. Water is then reintroduced to the contaminated line and the Colony
Forming Units (CFU) counts multiply within minutes. With a residual disinfectant present in the waterline it will remain free and clear of bacteria to a level concurrent with its EPA registered claim. So long as the water is not removed from the equation you have nothing to worry about. Remove the water and you remove the safeguard against bacteria growth. Always consult your EPA label beforehand. Chances are this practice is outlined in detail there if you are using a continuously present residual disinfectant.

2. No Stale Water
Almost every dental office has a chair that is not in regular use. Extended periods of inactivity can allow water to become stagnant in the lines. Over time residual disinfectants can lose their ability to keep bacteria at bay and soon the chair will have to be shocked to bring counts back to a manageable level. To alleviate this problem, you need only run a hand piece for a few seconds to refresh the residual disinfectant in your lines. If you are using tablets its best to make sure that water in the bottle is changed every 14 days. This practice of running water is best performed every other day, especially on Fridays if it’s not in regular use.

3. Regular Water Testing
So you’ve spent the money, trained your staff, and implemented the protocols. Now what? It’s time to verify. A periodic water test performed by a 3rd party lab is the only way to truly know if the steps you’ve taken are working. This is especially true if you have never had a protocol in place. Once you have established a baseline of CFU counts you may only need to test once a year. Don’t be surprised if you fail your initial test. It may take more than one shock and consistent maintenance for CFU counts to drop and stabilize. Manufacturers spent a lot of time and money to register products and effective claims with the EPA so that you can be confident in the steps you take. If you’re missing the mark, a water test will provide clues as to why.

4. Staff Training
This one cannot be emphasized enough. An EPA registered claim tells you what you can expect when it comes to disinfection. However, that claim is based on the steps laid out on the EPA label. If your staff aren’t following the proper directions, then you are “off label.” Not good. Regular training intervals will reinforce the procedure and help with consistency. If a step is missed, it’s time to shock and start over.
5. Regular Research
Disinfection techniques are constantly evolving becoming more convenient and cost effective with every new generation. It’s good to be in the know on what’s available to you. Right now there is no regulation on what is required but that will likely change in the future. The ADA, OSAP, and OSHA are great places to regularly look for the latest and greatest in disinfection protocols.
Share this post:




